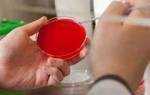

Что такое альфа-адреноблокаторы?
Адреноблокаторы представляют собой медикаменты, способные нейтрализовать адреналиновые рецепторы, находящиеся в сердце и кровеносных сосудах. Устраняются только те, которые отвечают за регуляцию адреналина и норадреналина. Каких эффектов это позволяет добиться:
- Расширения кровеносных сосудов
- Уменьшения артериального давления
- Уменьшения уровня сахара в крови
- Сужения просвета бронхов
- Снижения тонуса гладкомышечных тканей и мышц
Альфа-блокаторы при простатите относятся к группе с альфа-1-адреноблокаторами, т.е. они способны «выключать» только их альфа-1-адренорецепторы. К подобным препаратам относятся Альфузонин, Празозин, Тамсулозин. Существует ещё несколько групп медикаментов:
- Альфа-2-адреноблокаторы
- Альфа-1,2-адреноблокаторы
- Бета-1-адреноблокаторы
- Бета-1,2-адреноблокаторы
Каждый из них занимается выключением своих рецепторов, не затрагивая другие. Те, в которых присутствует 2 цифры, могут влиять сразу на несколько ферментов. Стандартными показаниями к применению рассматриваемых нами лекарств называют гипертонию, хроническую сердечную недостаточность, аденому предстательной железы. Простатит тоже можно отнести к данной группе, т.к. проявлениями он очень схож с доброкачественной гиперплазией.
Среди различных симптомов простатита присутствуют нарушения мочеиспускания – боли при походе в туалет, ощущение неполного опорожнения мочевого пузыря, прерывание струи и т.п. Альфа-адреноблокаторы при простатите предназначены для того, чтобы справляться именно с этими проявлениями недуга. Другие адренолитики могут повысить потенцию, избавить от головных болей, наладить мозговое кровообращение и устранить кислородное голодание. Противопоказаний и побочных эффектов у препаратов хватает, поэтому принимать их необходимо с осторожностью.
Приобрести средство в аптеке можно без рецепта врача, но это не значит, что нужно покупать и сразу же начинать лечение. Важно узнать причину простатита, узнать у врача, как избавиться от неё, и уже одновременно с этим купировать симптомы.
Альфа адреноблокаторы находятся в группе медицинских препаратов, воздействие которых направлено на снижение нервных импульсов, проходящих через адренергический синапс. Их работа основана на временном блокировании альфа1- и альфа2-адренорецепторов.
Широкое применение эти средства нашли в специальной системе лечения артериальной гипертензии, показав себя довольно эффективными препаратами. Альфа блокаторы в урологии дают возможность добиться лучшего мочеиспускания, что тем более важно во время заболеваний простаты.
- Классификация альфа адреноблокаторов
- Лечение альфа адреноблокаторами в урологии
- Лечение альфа адреноблокаторами в кардиологии
- Список наиболее популярных средств данной группы
- Противопоказания и побочное действие
- Эффект первой дозы
Альфа адреноблокаторы входят в группу лекарственных препаратов, чье действие направлено на замедление нервных импульсов, проходящих сквозь адренергический синапс. Их действие основано на временной блокировке α1— и α2-адренорецепторов.
Свое применение препараты нашли в особой системе лечения артериальной гипертензии, зарекомендовав себя достаточно эффективным средством. В урологии альфа блокаторы помогают добиться улучшения мочеиспускания, что особенно важно при заболеваниях предстательной железы.
Альфа-адреноблокаторы в урологии занимают важное место в лечении различных заболеваний, связанных с мочевыводящей системой. Врачи отмечают, что эти препараты эффективно расслабляют гладкую мускулатуру простаты и шейки мочевого пузыря, что способствует улучшению мочеиспускания у пациентов с доброкачественной гиперплазией простаты. Исследования показывают, что использование альфа-адреноблокаторов может значительно снизить симптомы, такие как затрудненное мочеиспускание и частые позывы.
Однако специалисты подчеркивают необходимость индивидуального подхода к каждому пациенту, так как возможны побочные эффекты, включая головокружение и снижение артериального давления. Врачи рекомендуют тщательно оценивать состояние здоровья пациентов и учитывать сопутствующие заболевания перед назначением терапии. В целом, альфа-адреноблокаторы остаются важным инструментом в арсенале урологов, способствуя улучшению качества жизни пациентов.
Альфа-адреноблокаторы в урологии вызывают множество обсуждений среди пациентов и специалистов. Многие отмечают их эффективность в лечении доброкачественной гиперплазии предстательной железы, что значительно улучшает качество жизни мужчин. Пользователи часто делятся положительными отзывами о снижении симптомов, таких как затрудненное мочеиспускание и частые позывы. Однако не обошлось и без критики: некоторые пациенты сталкиваются с побочными эффектами, такими как головокружение и усталость. Врачи подчеркивают важность индивидуального подхода при назначении этих препаратов, так как реакция на них может варьироваться. В целом, альфа-адреноблокаторы остаются популярным выбором в урологической практике, благодаря своей способности облегчать симптомы и улучшать общее состояние пациентов.

Альфа адреноблокаторы — их свойства и механизм действия
Результатом воздействия альфа1-адреноблокаторов на организм оказывается расширение артериол и мелких периферических кровеносных сосудов, что улучшает кровоток, снимает отечность и спазмы, а также производит на пациента выраженный гипотонический эффект. При простатите лучшие препараты – альфа1-адреноблокаторы, так как они направленно воздействуют на органы и ткани мочеполовой системы, что актуально как при аденоме простаты (с целью уменьшения объема железы), так и при воспалительном процессе в простате.
Отдельно нужно отметить, что воздействие данной группы препаратов на кровеносные сосуды окажется полезным для пациентов, страдающих от гипертонии, при этом ответной реакции в виде тахикардии или повышения ЧСС не происходит.
В то же время, адреноблокаторы такого типа не снижают артериальное давление у нормотоников, и потому не требуют дополнительной коррекции дозировки во время терапии. Фармакокинетика описываемых лекарственных средств, в среднем, схожа: быстрое усвоение организмом до 90% принятого препарата, активная метаболизация в печени, период полувыведения около 4-6 часов и вывод из организма метаболитов частично почками, частично через кишечник.
Главное заблуждение представителей мужского пола заключается в том, что крепкое здоровье будет сопровождать их на протяжении всей жизни.
- Болезненные ощущения в паху.
- Повышенная температура.
- Учащенное посещение туалета с малым количеством жидкости.
- Отсутствие эрекции.
Проявление симптомов у больного индивидуально, а хроническая форма заболевания имеет не выраженную симптоматику. Крайне важно вовремя обратиться к врачу, чтобы быстрее приступить к лечению.
Первые действуют одинаково на гладкую мускулатуру по всему телу. Являются менее популярными из-за множества побочных эффектов (гипотензия, нарушения пищеварения, запоры). Вторая же группа характеризуется точечным расслаблением мышечных волокон именно в тканях предстательной железы.
Альфа адреноблокаторы при простатите призваны облегчить течение заболевания, но не вылечить его. Это сугубо симптоматическая терапия.
После их применения наблюдаются следующие эффекты:
Вопрос-ответ

Что такое альфа-адреноблокаторы и как они действуют в урологии?
Альфа-адреноблокаторы — это группа лекарственных средств, которые блокируют альфа-адренорецепторы, что приводит к расслаблению гладкой мускулатуры и снижению тонуса сосудов. В урологии они используются для лечения заболеваний, таких как доброкачественная гиперплазия предстательной железы (ДГПЖ), так как помогают улучшить мочеиспускание, уменьшая обструкцию мочевых путей.
Какие побочные эффекты могут возникнуть при применении альфа-адреноблокаторов?
Побочные эффекты альфа-адреноблокаторов могут включать головокружение, усталость, головную боль, а также ортостатическую гипотензию (резкое падение артериального давления при смене положения тела). Важно обсудить возможные риски с врачом перед началом лечения.

Каковы основные препараты из группы альфа-адреноблокаторов, применяемые в урологии?
К основным альфа-адреноблокаторам, применяемым в урологии, относятся теразозин, доксазозин и алфузозин. Эти препараты помогают облегчить симптомы, связанные с ДГПЖ, и улучшают качество жизни пациентов, страдающих от затрудненного мочеиспускания.
Советы
СОВЕТ №1
Перед началом лечения альфа адреноблокаторами обязательно проконсультируйтесь с врачом. Эти препараты могут иметь противопоказания и взаимодействия с другими лекарственными средствами, поэтому важно получить индивидуальные рекомендации.
СОВЕТ №2
Обратите внимание на возможные побочные эффекты альфа адреноблокаторов, такие как головокружение, усталость или изменения артериального давления. Если вы заметили какие-либо нежелательные реакции, немедленно сообщите об этом своему врачу.
СОВЕТ №3
Следите за своим состоянием во время лечения. Регулярно проверяйте артериальное давление и другие показатели здоровья, чтобы убедиться, что препарат оказывает положительное влияние и не вызывает осложнений.
СОВЕТ №4
Не прекращайте прием альфа адреноблокаторов самостоятельно. Если вы хотите изменить схему лечения или прекратить прием, обязательно обсудите это с врачом, чтобы избежать возможных негативных последствий.